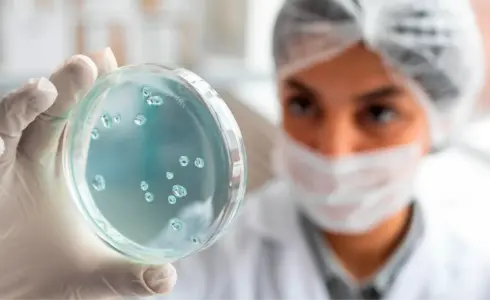
Portada Efemerides 2025 30 Enero 2

Tags

Día Mundial de la Justicia Social: Reflexión y Acción hacia un Futuro Equitativo
Por: Editorial UNICLA El 20 de febrero se conmemora el Día Mundial de la Justicia Social, proclamado por la Organización Internacional del Trabajo (OIT), un organismo especializado de las Naciones Unidas. Este evento resalta la importancia de promover la justicia social, la igualdad y el